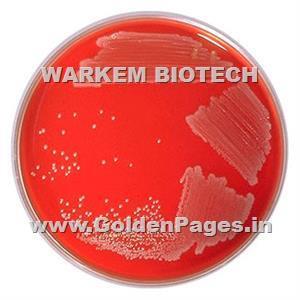

Home
Warkem Biotech is engaged in manufacturing hydrolyzed proteins and various bases meant for Microbiological, Pharmaceutical, Nutraceutical, Agriculture, Environmental,Fermentation, Cosmetic, Vaccine ,Veterinary and Environmental use. Refined series of various bacteriological ingredients are manufactured from various animal based proteins such as milk protein, soya, liver, gelatin etc. Single cell protein like yeast cells completes the full range of bacteriological raw materials required for culture media manufacturers, fermentation industries, vaccine manufacturing units, Biotechnology industries etc.
Products & Services
Highest quality standards are achieved through the implementations of latest technology, decades of experience and everlasting moral values , which have helped us to retain our customers as well as multiply them.